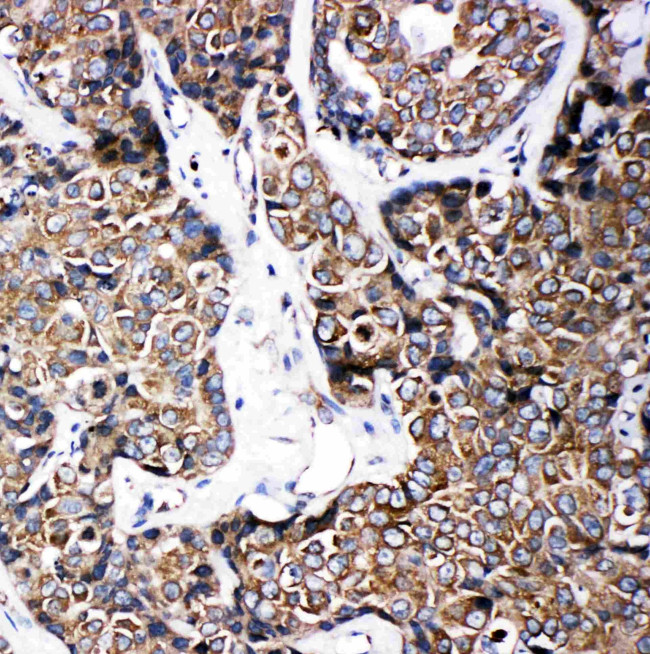
ABCB6 Antibody in Immunohistochemistry (Paraffin) (IHC (P))

Search
Invitrogen
ABCB6 Polyclonal Antibody
{{$productOrderCtrl.translations['antibody.pdp.commerceCard.promotion.promotions']}}
{{$productOrderCtrl.translations['antibody.pdp.commerceCard.promotion.viewpromo']}}
{{$productOrderCtrl.translations['antibody.pdp.commerceCard.promotion.promocode']}}: {{promo.promoCode}} {{promo.promoTitle}} {{promo.promoDescription}}. {{$productOrderCtrl.translations['antibody.pdp.commerceCard.promotion.learnmore']}}


Please note: We are reviewing Western blot images included in the antibody testing data in our catalog, including those provided by third parties. Unless expressly labeled or annotated as “raw-unedited”, Western blot images included in the antibody testing data in our catalog may have been edited, optimized or otherwise adjusted for presentation.
产品信息
PA5-78693
种属反应
已发表种属
宿主/亚型
分类
类型
抗原
偶联物
形式
浓度
规格
纯化类型
保存液
内含物
保存条件
运输条件
RRID
产品详细信息
Reconstitute with 0.2 mL of distilled water to yield a concentration of 500 µg/mL.
Positive Control - WB: HELA whole cell, MCF-7 whole cell, A549 whole cell. IHC: Human Mammary Cancer Tissue.
靶标信息
The membrane-associated protein encoded by this gene is a member of the superfamily of ATP-binding cassette transporters. ABC proteins transport various molecules across extra- and intra-cellular membranes. ABC genes are divided into seven distinct subfamilies. This protein is a member of the MDR/TAP subfamily. Members of the MDR/TAP subfamily are involved in multidrug resistance as well as antigen presentation. This half-transporter likely plays a role in mitochondrial function. Localized to 2q26, this gene is considered a candidate gene for lethal neonatal metabolic syndrome, a disorder of mitochondrial function.
⚠WARNING: This product can expose you to chemicals including mercury, which is known to the State of California to cause birth defects or other reproductive harm. For more information go to www.P65Warnings.ca.gov.
仅用于科研。不用于诊断过程。未经明确授权不得转售。
生物信息学
蛋白别名: ABC-type heme transporter ABCB6; ATP-binding cassette sub-family B member 6; EST45597; FLJ22414; Mitochondrial ABC transporter 3; Mt-ABC transporter 3; P-glycoprotein-related protein; Ubiquitously-expressed mammalian ABC half transporter
基因别名: ABCB6; MTABC3; PRP; UMAT
Entrez Gene ID: (Human) 10058